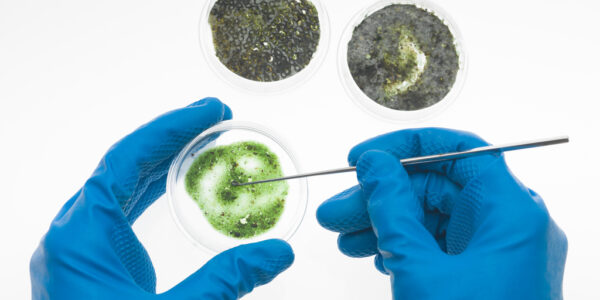

Mold Inspection and Assessment Toronto
At Mold Assist, we provide expert mold inspection and assessment services in Toronto, ensuring homes and businesses across the Greater Toronto Area (GTA) are safe from the risks of mold growth. Toronto’s humid climate, with summer dew points often exceeding 20°C and wet winters with frequent freeze-thaw cycles, creates ideal conditions for mold contamination. Mold can compromise indoor air quality, trigger health issues like allergies or respiratory problems, and cause structural damage to properties. Our IICRC-certified team uses cutting-edge technology and industry-leading protocols to deliver precise mold inspections and actionable solutions, in line with standards from the Institute of Inspection Cleaning and Restoration Certification (IICRC). With over 15 years of experience, we offer rapid, reliable services across Toronto, North York, Scarborough, Vaughan, Etobicoke, Mississauga, Markham, Richmond Hill, Brampton, and surrounding areas. Contact us at (866) 916-4677 or visit moldassist.ca to schedule your mold inspection Toronto and protect your property today.
Why Mold Inspection and Assessment Matters in Toronto
Mold thrives in damp, humid environments, and Toronto’s climate makes it a hotspot for mold growth. From humid summers to wet winters, conditions like poor ventilation, water leaks, or flooding in basements and attics can lead to hidden mold issues. Left unchecked, mold can spread rapidly, releasing mold spores that degrade air quality and pose health risks, especially for children, seniors, or those with respiratory conditions. A professional mold inspection is the first step to identifying these risks and preventing costly damage to your property, as outlined in Health Canada’s Residential Indoor Air Quality Guideline: Moulds.
At Mold Assist, our mold assessment GTA services are designed to detect mold early, assess its severity, and provide clear recommendations for remediation. Whether you’re a homeowner in Rosedale, a landlord in Scarborough, or a business owner in Toronto’s Financial District, our inspections ensure your property remains safe, healthy, and compliant with industry standards.
Common Signs You Need a Mold Inspection:
- Persistent musty odors in basements, bathrooms, or attics
- Visible mold growth on walls, ceilings, or floors
- Recent water damage from leaks, flooding, or poor drainage
- Unexplained health symptoms like coughing, sneezing, or skin irritation
- Poor ventilation in condos, older homes, or commercial spaces
Our professional mold inspectors in Toronto use advanced tools to uncover hidden mold and provide peace of mind with comprehensive assessments.
Why Choose Mold Assist for Mold Inspection in Toronto?
When it comes to mold inspection Toronto, Mold Assist stands out as the trusted choice for GTA residents and businesses. Our IICRC-certified team combines local expertise, advanced technology, and a customer-centric approach to deliver exceptional results, following the ANSI/IICRC S520 Standard for Professional Mold Remediation. Here’s why we’re the preferred provider for mold assessment GTA:
- Rapid Response: We offer a 60-minute response time across Toronto, North York, Mississauga, and other GTA areas, ensuring prompt inspections to address mold concerns quickly.
- IICRC-Certified Expertise: Our technicians are certified by the Institute of Inspection Cleaning and Restoration Certification (IICRC), adhering to strict industry standards for mold inspections and assessments.
- Advanced Diagnostic Tools: We use thermal imaging cameras, moisture meters, and air sampling equipment to detect hidden mold and moisture sources, even in hard-to-reach areas like crawlspaces or HVAC systems.
- Detailed Reporting: Every inspection includes a comprehensive digital report with photos, findings, and tailored recommendations for mold remediation if needed.
- Eco-Friendly Practices: We prioritize safe, non-toxic methods to ensure the health of your family, pets, and the environment during our mold assessments.
- Local Knowledge: With deep understanding of Toronto’s climate and building types, we address common issues like high humidity in Brampton basements or poor ventilation in North York condos.
Our commitment to transparency, reliability, and customer satisfaction makes Mold Assist the go-to choice for mold inspection services in Toronto.
Our Mold Inspection and Assessment Process
At Mold Assist, we follow a meticulous, IICRC-compliant process for mold inspection and assessment Toronto to ensure accurate results and minimal disruption. Our systematic approach identifies mold issues, assesses risks, and provides clear next steps, aligned with Ontario’s guidelines for laboratories offering mould and mycotoxin analysis.
1. Initial Consultation and Property Review
We start by discussing your concerns and reviewing your property’s history, including any past water damage, leaks, or ventilation issues. This helps us customize our mold inspection to your specific needs, whether it’s a century-old home in the Annex or a modern office in Markham.
2. Thorough Visual Inspection
Our professional mold inspectors conduct a detailed visual examination of your property, checking for signs of mold growth, water stains, or conditions conducive to mold. We inspect high-risk areas like basements, attics, bathrooms, kitchens, and HVAC systems, where mold often thrives in Toronto’s humid climate.
3. Advanced Diagnostic Testing
To uncover hidden mold issues, we use state-of-the-art tools, including:
- Thermal imaging cameras to detect moisture behind walls or ceilings
- Moisture meters to measure humidity levels in materials
- Air sampling equipment to analyze mold spore concentrations in the air
These tools ensure precision, even in areas where mold is not visible to the naked eye.
4. Sample Collection and Laboratory Analysis
If mold is suspected, we may collect surface or air samples for laboratory testing to identify the type and concentration of mold. This step is critical for developing an effective mold remediation plan and ensuring the safety of your indoor environment. We partner with reputable labs like Mold & Bacteria Consulting Laboratories (MBL) for accurate, AIHA-accredited analysis.
5. Comprehensive Report and Recommendations
After the inspection, we provide a detailed digital report with photos, findings, and actionable recommendations. If mold remediation is required, we guide you through the next steps or connect you with trusted professionals in Toronto. Our reports are clear, transparent, and designed to help you make informed decisions.
6. Follow-Up Support
We offer ongoing support to answer questions and ensure your mold concerns are fully addressed. Our goal is to restore your confidence in the safety and health of your property.
This process, typically completed in 1–2 days, ensures thorough results with minimal disruption to your home or business.
Health and Safety Risks of Mold in Toronto
Mold is more than a cosmetic issue—it can pose significant health risks. According to the American Lung Association’s resources on mold, exposure to mold spores increases the risk of respiratory issues by 25–30% in humid urban areas like Toronto. Common health symptoms include:
- Allergic reactions (sneezing, itchy eyes, skin rashes)
- Respiratory problems (coughing, wheezing, asthma exacerbation)
- Headaches or fatigue
- Chronic sinus infections
Vulnerable populations, such as children, seniors, or those with weakened immune systems, are particularly at risk. Our mold inspection services identify these hazards early, allowing you to take proactive steps to protect your health and property, as recommended in Health Canada’s guide to addressing moisture and mould indoors.
Mold Inspection for Residential and Commercial Properties
Mold Assist provides tailored mold inspection and assessment services for both residential and commercial properties in Toronto. Our expertise ensures that every property, from historic homes to modern office spaces, is thoroughly evaluated for mold growth, in compliance with Ontario’s alert on mould in workplace buildings.
Residential Mold Inspections
Your home should be a safe, healthy environment. Our residential mold inspections focus on high-risk areas like basements, bathrooms, attics, and crawlspaces. We address common Toronto issues, such as humidity in Scarborough homes or poor ventilation in North York condos, to ensure your family’s safety.
Commercial Mold Inspections
For businesses, mold issues can lead to employee health complaints, reduced productivity, or even regulatory fines under Ontario’s Occupational Health and Safety Act (OHSA). Our commercial mold assessments are discreet and efficient, minimizing disruptions to your operations in Toronto’s Financial District, Markham offices, or Vaughan warehouses.
Common Causes of Mold Growth in Toronto
Toronto’s unique climate and building characteristics contribute to mold growth. Our mold inspections address the following common causes:
- High Humidity: Summer humidity levels above 60% in areas like Mississauga or Brampton.
- Water Leaks: Plumbing or roof leaks in older homes in Rosedale or Leslieville.
- Poor Ventilation: Sealed condos in North York or downtown Toronto trap moisture.
- Flooding: Heavy rainfall in Scarborough or snowmelt in Etobicoke.
- Aging Infrastructure: Cracks or poor insulation in century-old homes or commercial buildings.
By identifying these triggers, Mold Assist helps prevent mold contamination and protects your property’s value in Toronto’s competitive real estate market, drawing on insights from the U.S. EPA’s mold testing resources.
Cost of Mold Inspection and Assessment in Toronto (2025)
The cost of mold inspection Toronto ranges from $500 to $2,500, depending on:
- Property Size: Larger homes or commercial spaces require more extensive inspections.
- Severity of Issue: Hidden mold or multiple affected areas may need additional testing.
- Testing Requirements: Air or surface sampling for lab analysis adds to the cost.
- Urgency: Emergency inspections may incur a 15–20% premium.
At Mold Assist, basic mold inspections start at $500, with comprehensive assessments averaging $1,000–$1,500 for residential properties and $1,500–$2,500 for commercial spaces.
| Service Type |
Avg. Cost (CAD) |
Inclusions |
| Basic Mold Inspection |
$500–$1,000 |
Visual inspection, moisture testing |
| Comprehensive Assessment |
$1,000–$2,500 |
Visual, air sampling, detailed report |
| Commercial Inspection |
$1,500–$3,500 |
Large-scale, compliance-focused inspections |
Service Areas for Mold Inspection in Toronto
We provide mold inspection and assessment services across the GTA, including:
- Toronto Downtown
- North York
- Scarborough
- Vaughan
- Etobicoke
- Mississauga
- Markham
- Richmond Hill
- Brampton
Our 90-minute response time ensures prompt service throughout the region.
Maintaining a Mold-Free Environment in Toronto
To prevent mold growth after an inspection:
- Use dehumidifiers to maintain humidity below 50%.
- Improve ventilation with exhaust fans or open windows.
- Address leaks or water damage promptly.
- Schedule regular mold inspections with Mold Assist to monitor high-risk areas.
Testimonials from Satisfied Clients
“Mold Assist identified hidden mold in our Etobicoke basement with their thermal imaging tools. Their detailed report helped us act fast!” – Sarah T., Etobicoke “Their mold inspection in our Markham office was thorough and professional. Highly recommend!” – David L., Markham
Schedule Your Mold Inspection Today
Don’t let mold issues compromise your health or property. Contact Mold Assist at (866) 916-4677 or send us a message to schedule your mold inspection and assessment Toronto. Our IICRC-certified team is ready to deliver fast, reliable solutions to restore a safe, healthy environment across the GTA.